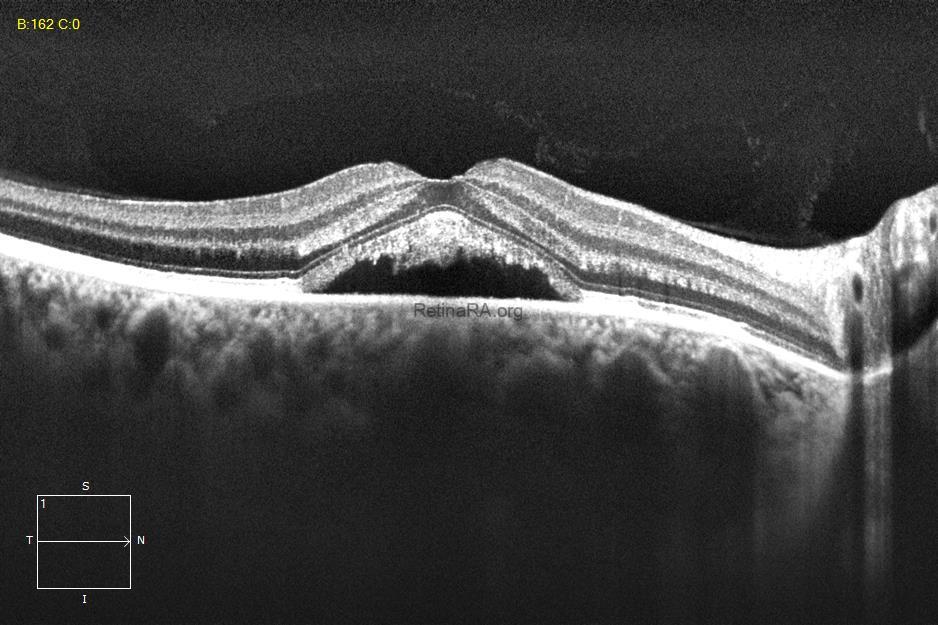

A 36-year-old male patient began complaining of decreased vision in his right eye 4 months ago and was diagnosed with central serous chorioretinopathy (CSCR). The patient’s visual acuity, which was 20/32, improved to 20/20 again after subthreshold laser treatment.
Pre-treatment OCT, fundus autofluorescence image (FAF), and fluorescein angiography (FA) of a patient with CSCR

Subretinal fluid, photoreceptor elongation, and pachyvessels (red arrows) were observed in OCT.

FAF showed hyper-autofluorescence dots in the macula, as well as another focus of CSCR on the nasal side of the optic disc.


An inkblot pattern leakage was observed on early and mid-late phase FA images. Subthreshold laser treatment was applied to only leakage point.
OCT and fundus autofluorescence image of a patient with CSCR at 2 weeks post-treatment


After 2 weeks of subthreshold laser treatment, the subretinal fluid decreased and a vitelliform material was formed both on OCT and FAF.
OCT and fundus autofluorescence image of a patient with CSCR at 5 weeks post-treatment


After 5 weeks of subthreshold laser treatment, the subretinal fluid was completely resolved but the vitelliform material was still observed on FAF.
Credit: M. Giray Ersoz, MD, FEBO, Retina Specialist
Memorial Bahçelievler Hospital, Department of Ophthalmology, Istanbul, Turkey
Arel University School of Medicine, Department of Ophthalmology, Istanbul, Turkey
Instagram accounts: @retina.review and @retina.dr.girayersoz
Website: www.girayersoz.com.tr